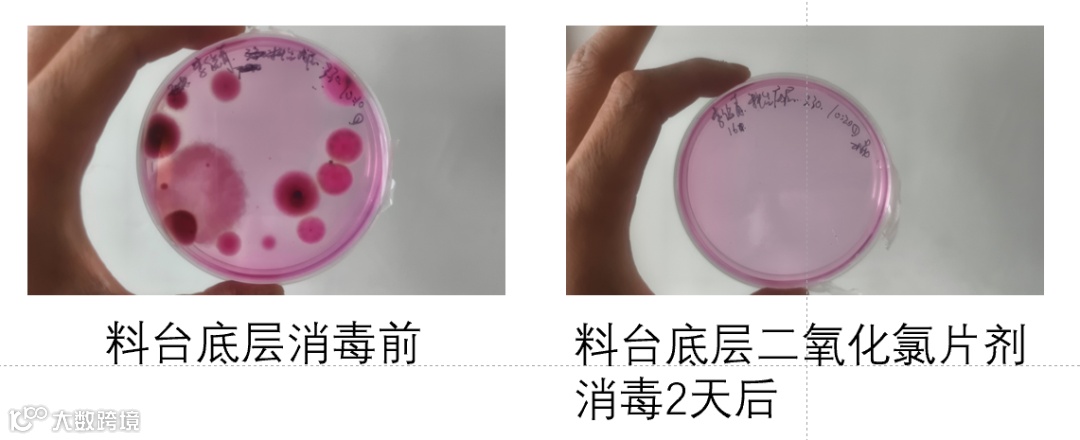

文 | 图
动保事业部 余志华
盐城海维 唐杨
摘要:行情向好,鮰鱼越冬管理不当易造成大损失,结合一线调研,拆解风险点,给出鮰鱼越冬管理方案,助养户养殖安全越冬、保成活率、稳收益!
一
行情趋势向好,提升成活率成为鮰鱼养殖增效的关键。每年的越冬综合征爆发导致不少养户承受巨大损失,安全越冬就是保住一年的养殖成果,守住即将到手的钱袋子,结合2025年盐城海维团队调研的一线数据结果,剖析影响越冬安全的原因及应对方案,一起打赢这场越冬保卫战!

2025年早春病害发生情况表

二
开春后的水霉病(1-2月)和越冬综合征(3-4月)根源往往并非出自春季本身,而是整个冬季管理过程中一系列未被重视的风险点累积所致。这些风险如同“隐形杀手”,在整个越冬期不断滋生、发展,最终在气温回升时集中爆发,造成难以挽回的损失。

水霉病 越冬综合征损鱼
为了帮助大家系统性的识别并防范这些风险,我们将越冬前、中、后期全过程中可能遇到的核心问题及其直接后果梳理如下表。

三
针对上述的内因外因,我们不难发现,所有风险最终都指向两个核心管理对象:鱼体与水环境。因此,我们的应对策略也必须“双管齐下”,明确管理重点:
鮰鱼体质(强体):越冬前“培元固本”,越冬中“保膘护体”,越冬后“恢复强健”;
水质、底质(水环境稳定、控制病原):保证水体透明度、藻相和溶氧,减少池塘中水霉菌、细菌等病原体的数量。

1、越冬前期方案
1)尽量减少动网和放苗,越冬前进行寄生虫检查,及时杀虫,减少鮰鱼受伤之后越冬的风险。
2)在投喂上做好内服保健,使用鮰鱼功能料鱼健康1号,搭配103/505拌喂或者直接拌喂肝肠利健微软,提高鮰鱼体质避免带病越冬。

早春的调研结果显示带病越冬和低温放苗在4月份发病风险极大。

3)水体与底质管理
越冬前通过多次少量换水等操作调理水质,将水位调至1.8米以上。
精准施肥:培养优质藻类,藻生元+藻源素 ,20亩*米/组。维持水体稳定和池塘溶氧。


水霉在池塘中的分布特点
减少池塘底部病菌,菌速清Ⅰ型,3-4亩•米/包,20天/次;池塘改底,底倍健(40亩/箱)+粒粒氧(2-3亩•米/包),30天/次。

二氧化氯片剂消毒效果


2、 越冬中期方案
1)投喂管理:少量定期投喂0.1%左右(3-5天/次),定期拌喂肝肠利健,维持肝肠功能,温度过低结冰停喂。
2)水质底质管理:
定期改底: 每月至少使用一次底倍健+粒粒氧,分解底部废物。
定期消毒:推荐使用片剂消毒,菌速清Ⅰ型/好易典30天/次。
3)巡塘:勤巡塘,发现问题及时介入解决,在极端天气下可全池泼洒应激灵,防止鱼体冻伤和强应激。


3、 越冬后期方案
1)投喂:温度上升投喂率提升不可过快,投喂保健料拌服肝肠利健。
2)水质底质管理:
提升消毒频率(15天/次,视情况增加频率);
天气波动大水瘦水质差做好肥水稳水;
选择片剂和水剂消毒剂搭配使用;
投喂量增加提高改底频率。
总结:鮰鱼越冬问题由多因素累积引发,需围绕鱼体与水环境,在越冬前中后各阶段采用针对性方案,系统管理才能规避损失。
如果您有养殖方面的困惑或产品需求,可扫码留言咨询。

本文系海大农牧原创,未经授权,一律禁止转载!文章投稿、转载授权,欢迎发邮件到:haidnm@haid.com.cn
👇 咨询产品可点击"阅读原文"留言



